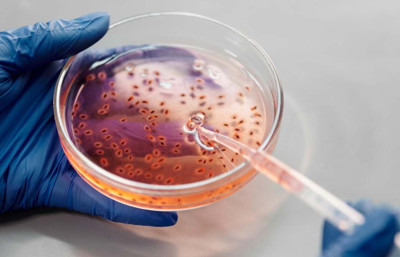
ABD'de daha önce insanlarda görülmeyen virüs can aldı!

Dünya haberleri ve son dakika sıcak gelişmeleri dış haberler ekibimiz ve yurt dışı haber kaynaklarımızdan sıcak gelişmeler anında dunya.com'da.
Dünya Haberleri
İsrail yine ateşkesi ihlal etti! Beyrut'a hava saldırısı
İsrail ordusu, Lübnan ile İsrail arasında yürürlükte olan ateşkese rağmen Beyrut'un Dahiye bölgesine hava saldırısı düzenledi. İsrail, saldırının Hizbullah'ın üst düzey bir ismini hedef aldığını öne...

ABD'de daha önce insanlarda görülmeyen virüs can aldı!
ABD'de kuş gribinin daha önce insanda bildirilmeyen bir türüne yakalanan yaşlı hasta kısa bir süre sonra hayatını kaybetti. Bu vaka ABD'de kuş gribinden ikinci ölüm olarak kayıtlara...

Çin'de doğrudan yabancı yatırımlarda düşüş devam ediyor
Çin Ticaret Bakanlığı, ülkeye yönelik doğrudan yabancı yatırımların Ocak-Ekim 2025 döneminde 621,9 milyar yuan seviyesinde gerçekleştiğini ve yıllık bazda yüzde 10,3 gerilediğini açıkladı. Genel...
Suudi Arabistan’ın 1 trilyon dolarlık yatırım sözünün perde arkasındaki nakit sıkıntısı
Suudi Arabistan Veliaht Prensi Muhammed bin Selman’ın Washington ziyareti sırasında ABD’ye 1 trilyon dolarlık yatırım taahhüdünde bulunması, krallığın küresel güç imajını güçlendirmeyi amaçlayan...
Cumhurbaşkanı Erdoğan ve Macron G20 Zirvesi'nde bir araya geldi
Cumhurbaşkanı Recep Tayyip Erdoğan, G20 Liderler Zirvesi için bulunduğu Güney Afrika'da Fransa Cumhurbaşkanı Emmanuel Macron ile görüştü. İki lider, Türkiye–Fransa ilişkilerinin geliştirilmesine yönelik adımlar ile bölgesel ve küresel gündemi ele aldı. Erdoğan, Gazze’de ateşkesin korunmasının ve insani yardımların ulaştırılmasının önemini vurgularken, kalıcı barışın ancak iki devletli çözümle mümkün olacağını belirtti.
Moody’s, İtalya’nın kredi notunu 23 yıl sonra ilk kez yükseltti
Uluslararası kredi derecelendirme kuruluşu Moody’s, İtalya’nın kredi notunu Baa3’ten Baa2’ye yükseltti. Kuruluş, not artırımının gerekçesi olarak ülkenin “tutarlı siyasi çizgisi ve politika istikrarı” ile Ulusal Kurtarma ve Dayanıklılık Planı’ndaki ilerlemeyi gösterdi.
Eindhoven Havalimanı’nda dron alarmı
Hollanda'nın Eindhoven Havalimanı’nda birden fazla dron tespit edilmesi üzerine sivil ve askeri hava trafiği geçici olarak durduruldu. Olay, Hollanda Savunma Bakanı Ruben Brekelmans’ın sosyal medya hesabından yaptığı açıklamayla duyuruldu.
Vietnam'daki sel felaketinde can kaybı 90'a yükseldi
Vietnam'da günlerdir etkili olan şiddetli yağışların yol açtığı sel felaketinde can kaybı 90'a yükseldi. Tarım ve Çevre Bakanlığı'na bağlı Afet Önleme ve Kontrol Dairesi, 12 kişiden hâlâ haber alınamadığını ve bölgede arama-kurtarma çalışmalarının sürdüğünü açıkladı. Ülkede 1154 ev sel nedeniyle hasar görürken, 1 milyondan fazla hanede elektrik kesintisi yaşandı. Toplam maddi hasarın 341 milyon dolar seviyesinde olduğu tahmin ediliyor.
G20 Liderler Zirvesi'nin sonuç bildirisi yayınlandı
G20 liderleri, ABD'nin itirazlarına rağmen Johannesburg'daki zirvenin ilk gününde uluslararası hukuka bağlılık, çatışmaların sona erdirilmesi, gıda güvenliği, kritik mineraller ve finansal istikrar...

Veri merkezlerinin dev enerji açığını fırsata çevirecek
Veri merkezlerine enerji sağlamak için enerji santrallerinin inşasını hızlandırmak isteyen sosyal medya devi Meta, elektrik ticareti işine girmeyi planlıyor. Şirket elektrik ticareti için lisans...



Gazze: İsrail, ateşkesi 497 kez ihlal ederek 342 Filistinliyi öldürdü
Gazze Hükümeti, İsrail ordusunun 10 Ekim'den bu yana yürürlükte olan ateşkes anlaşmasını 497 kez ihlal ettiğini ve bu ihlaller sonucu 342 Filistinlinin hayatını kaybettiğini duyurdu.
Venezuela: Tüm tehditlerine "başı dik" karşılık veriyoruz
Venezuela Savunma Bakanı Vladimir Padrino Lopez, ABD'nin haftalardır sürdürdüğü tüm tehditlere ülkesinin "başı dik bir şekilde karşılık verdiğini" belirtti. Washington’un savaş gemileri ve nükleer...



